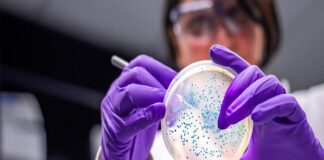
OMS avisa de la creciente resistencia de bacterias infecciosas a fármacos

Etiqueta: antibiótico
OMS avisa de la creciente resistencia de bacterias infecciosas a fármacos
MADRID.- La Organización Mundial de la Salud (OMS) ha publicado un informe en el que alerta del "elevado" aumento de las resistencias a los...
Derechos Reservados La Red Noticias 2025 Contáctanos: [email protected]
Desarrollado por cuuapp.mx Hospedado en Cloudways